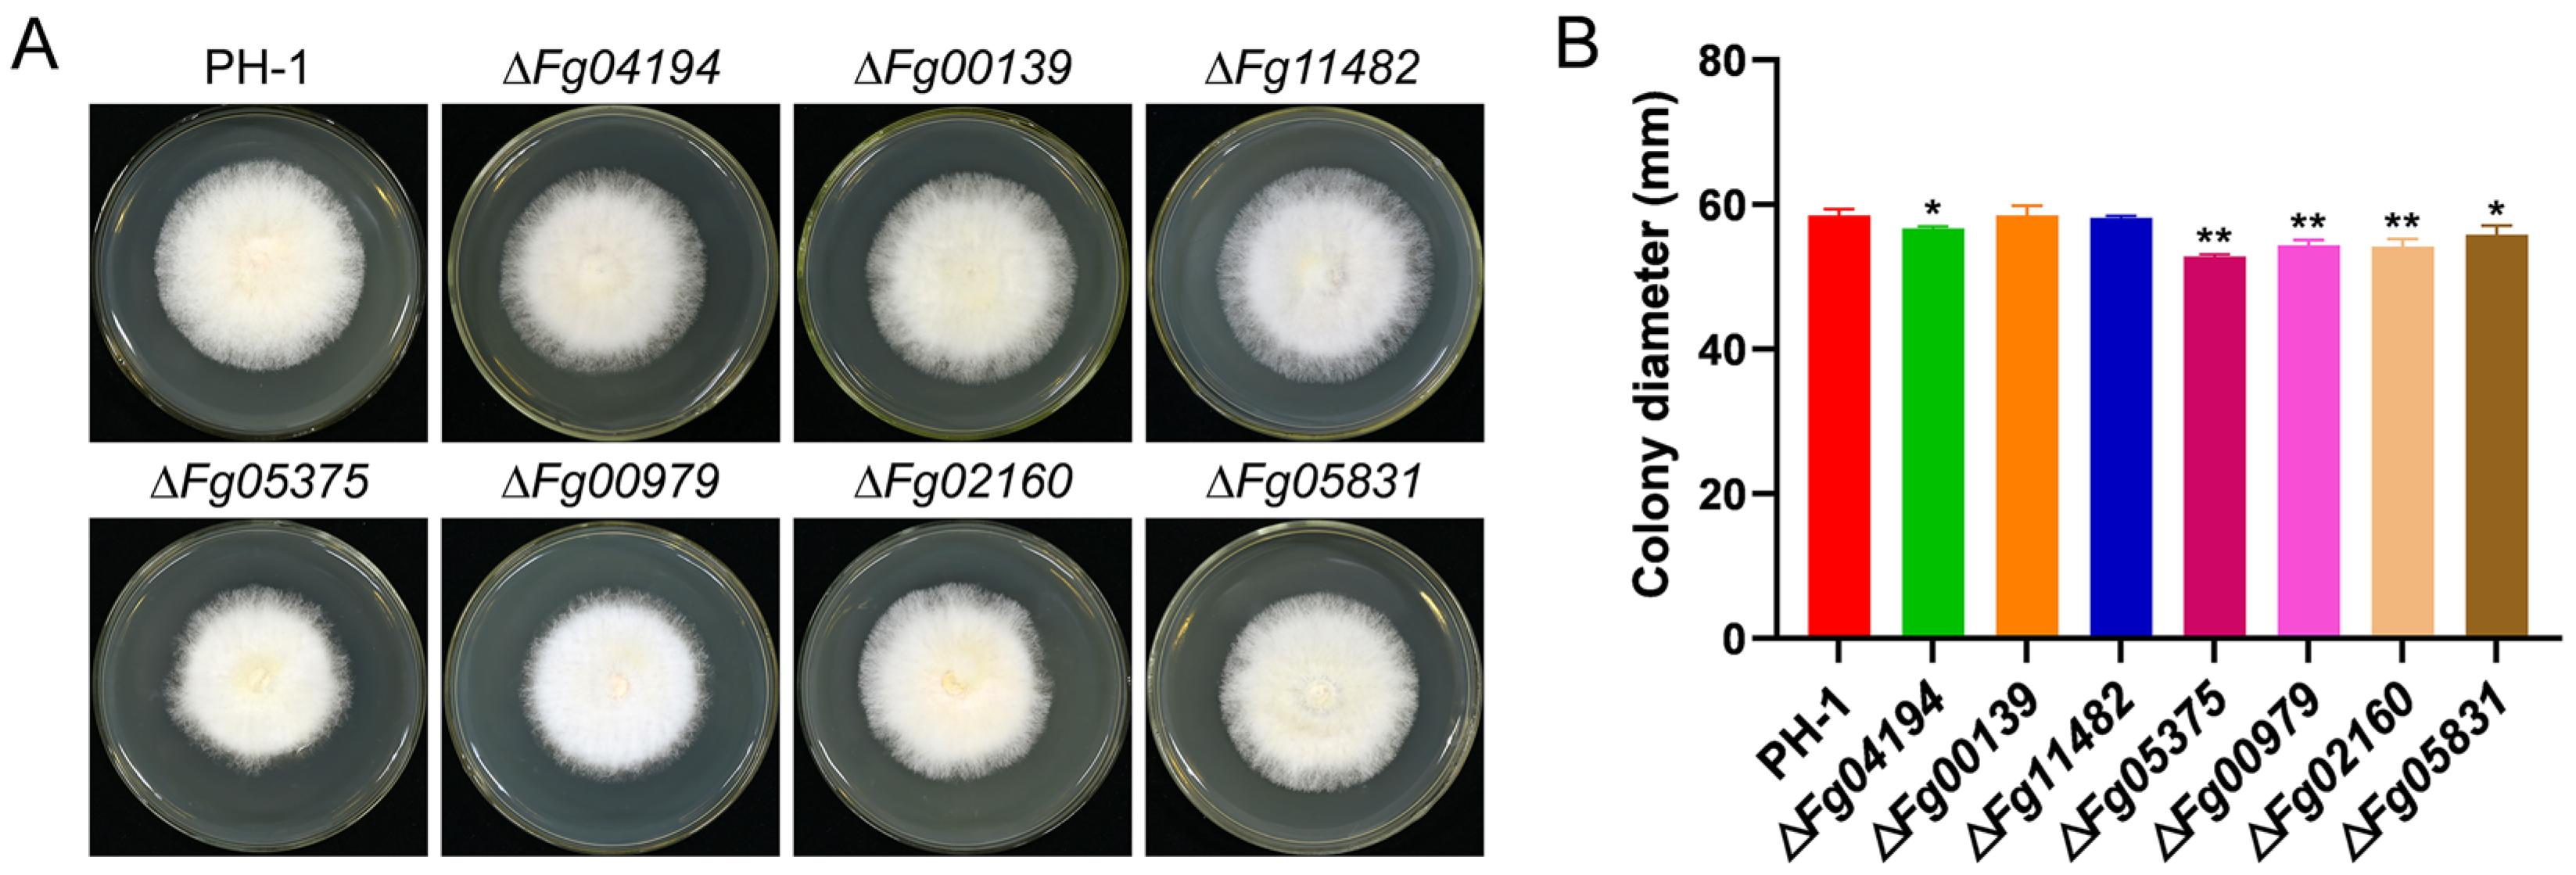
Microorganisms 11 02875 g003

Functional Characterization of Aldehyde Dehydrogenase in Fusarium graminearum
Abstract
:1. Introduction
2. Materials and Methods
2.1. Strains and Culture Conditions
2.2. Identification of the ALDH in F. graminearum
2.3. Construction of Deletion and Complementary Mutants
2.4. Fungal Growth and Conidia Production Analysis
2.5. Response of the Knockdown Mutants to Stress
2.6. Pathogenicity and DON Synthesis Analysis
2.7. Determination of ALDH Activity, SDH Activity, and ATP Content
2.8. Transcriptomic Analysis
2.9. Real-Time PCR Validation
2.10. Analysis of Subcellular Localization and Lipid Droplet Accumulation
2.11. Statistical Analysis
3. Results
3.1. Analysis of ALDH Homologous Sequences in F. graminearum
3.2. ALDH Genes Have Various Roles in the Regulation of Acetaldehyde Dehydrogenase Activity
3.3. ALDH Has an Effect on Mycelia Growth
3.4. ALDH Has a Role in Regulating Conidiogenesis in F. graminearum
3.5. ALDHs Regulate Environmental Stress Responses
3.6. ALDH Is Necessary for F. graminearum Pathogenicity and Deoxynivalenol Biosynthesis
3.7. ALDH Is Important for Mitochondrial Function
3.8. Transcriptomic Analysis of ΔFg04194
3.9. FGSG_04194 Is Localized to Lipid Droplets and Is Crucial for Their Accumulation
4. Discussion
5. Conclusions
Supplementary Materials
Author Contributions
Funding
Institutional Review Board Statement
Informed Consent Statement
Data Availability Statement
Acknowledgments
Conflicts of Interest
References
- Vasiliou, V.; Bairoch, A.; Tipton, K.F.; Nebert, D.W. Eukaryotic aldehyde dehydrogenase (ALDH) genes: Human polymorphisms, and recommended nomenclature based on divergent evolution and chromosomal mapping. Pharmacogenetics 1999, 9, 421–434. [Google Scholar] [CrossRef] [PubMed]
- Lo, H.F.; Su, J.Y.; Chen, H.L.; Chen, J.C.; Lin, L.L. Biophysical studies of an NAD(P)(+)-dependent aldehyde dehydrogenase from Bacillus licheniformis. Eur. Biophys. J. 2011, 40, 1131–1142. [Google Scholar] [CrossRef] [PubMed]
- Guo, X.; Wang, Y.; Lu, H.; Cai, X.; Wang, X.; Zhou, Z.; Wang, C.; Wang, Y.; Zhang, Z.; Wang, K.; et al. Genome-wide characterization and expression analysis of the aldehyde dehydrogenase (ALDH) gene superfamily under abiotic stresses in cotton. Gene 2017, 628, 230–245. [Google Scholar] [CrossRef] [PubMed]
- Gao, C.; Han, B. Evolutionary and expression study of the aldehyde dehydrogenase (ALDH) gene superfamily in rice (Oryza sativa). Gene 2008, 431, 86–94. [Google Scholar] [CrossRef] [PubMed]
- Kirch, H.-H.; Bartels, D.; Wei, Y.; Schnable, P.S.; Wood, A.J. The ALDH gene superfamily of Arabidopsis. Trends Plant Sci. 2004, 9, 371–377. [Google Scholar] [CrossRef] [PubMed]
- Zhang, Y.; Mao, L.; Wang, H.; Brocker, C.; Yin, X.; Vasiliou, V.; Fei, Z.; Wang, X. Genome-wide identification and analysis of grape aldehyde dehydrogenase (ALDH) gene superfamily. PLoS ONE 2012, 7, e32153. [Google Scholar] [CrossRef] [PubMed]
- Vasiliou, V.; Nebert, D.W. Analysis and update of the human aldehyde dehydrogenase (ALDH) gene family. Hum. Genom. 2005, 2, 138–143. [Google Scholar] [CrossRef]
- Marchitti, S.A.; Brocker, C.; Stagos, D.; Vasiliou, V. Non-P450 aldehyde oxidizing enzymes: The aldehyde dehydrogenase superfamily. Expert Opin. Drug Metab. Toxicol. 2008, 4, 697–720. [Google Scholar] [CrossRef]
- Singh, S.; Brocker, C.; Koppaka, V.; Chen, Y.; Jackson, B.C.; Matsumoto, A.; Thompson, D.C.; Vasiliou, V. Aldehyde dehydrogenases in cellular responses to oxidative/electrophilic stress. Free Radic. Biol. Med. 2013, 56, 89–101. [Google Scholar] [CrossRef]
- Norvienyeku, J.; Zhong, Z.; Lin, L.; Dang, X.; Chen, M.; Lin, X.; Zhang, H.; Anjago, W.M.; Lin, L.; Abdul, W.; et al. Methylmalonate-semialdehyde dehydrogenase mediated metabolite homeostasis essentially regulate conidiation, polarized germination and pathogenesis in Magnaporthe oryzae. Environ. Microbiol. 2017, 19, 4256–4277. [Google Scholar] [CrossRef]
- Felczak, M.M.; TerAvest, M.A. Zymomonas mobilis ZM4 Utilizes an NADP+-Dependent Acetaldehyde Dehydrogenase to Produce Acetate. J. Bacteriol. 2022, 204, e0056321. [Google Scholar] [CrossRef] [PubMed]
- Jun-Hye, S.; Sung-Ryul, K.; Gynheung, A. Rice aldehyde dehydrogenase7 is needed for seed maturation and viability. Plant Physiol. 2009, 149, 905–915. [Google Scholar] [CrossRef]
- Nakazono, M.; Tsuji, H.; Li, Y.; Saisho, D.; Arimura, S.; Tsutsumi, N.; Hirai, A. Expression of a gene encoding mitochondrial aldehyde dehydrogenase in rice increases under submerged conditions. Plant Physiol. 2000, 124, 587–598. [Google Scholar] [CrossRef] [PubMed]
- Xie, X.; Zhang, Z.; Zhao, Z.; Xie, Y.; Li, H.; Ma, X.; Liu, Y.G.; Chen, L. The mitochondrial aldehyde dehydrogenase OsALDH2b negatively regulates tapetum degeneration in rice. J. Exp. Bot. 2020, 71, 2551–2560. [Google Scholar] [CrossRef] [PubMed]
- Guan, Y.; Tanwar, U.K.; Sobieszczuk, N.E.; Floryszak, W.J.; Arasimowicz, J.M. Comparative genomic analysis of the aldehyde dehydrogenase gene superfamily in Arabidopsis thaliana—Searching for the functional key to hypoxia tolerance. Front. Plant Sci. 2022, 13, 1000024. [Google Scholar] [CrossRef] [PubMed]
- Zhang, J.; Guo, Y.; Zhao, X.; Pang, J.; Pan, C.; Wang, J.; Wei, S.; Yu, X.; Zhang, C.; Chen, Y.; et al. The role of aldehyde dehydrogenase 2 in cardiovascular disease. Nat. Rev. Cardiol. 2023, 20, 495–509. [Google Scholar] [CrossRef] [PubMed]
- Ling, M.; Huang, C.; Hua, T.; Li, H.; Xiao, W.; Lu, Z.; Jia, D.; Zhou, W.; Zhang, L.; Yang, M. Acetaldehyde dehydrogenase 2 activation attenuates sepsis-induced brain injury through NLRP3 inflammasome regulation. Brain Res. Bull. 2023, 194, 128–138. [Google Scholar] [CrossRef]
- Agustín, A.; del Olmo, M. Response to acetaldehyde stress in the yeast Saccharomyces cerevisiae involves a strain-dependent regulation of several ALD genes and is mediated by the general stress response pathway. Yeast 2003, 20, 747–759. [Google Scholar] [CrossRef]
- Navarro-Aviño, J.P.; Prasad, R.; Miralles, V.J.; Benito, R.M.; Serrano, R. A proposal for nomenclature of aldehyde dehydrogenases in Saccharomyces cerevisiae and characterization of the stress-inducible ALD2 and ALD3 genes. Yeast 1999, 15, 829–842. [Google Scholar] [CrossRef]
- Mukhopadhyay, A.; Wei, B.; Weiner, H. Mitochondrial NAD dependent aldehyde dehydrogenase either from yeast or human replaces yeast cytoplasmic NADP dependent aldehyde dehydrogenase for the aerobic growth of yeast on ethanol. Biochim. Biophys. Acta 2013, 1830, 3391–3398. [Google Scholar] [CrossRef]
- Abdul, W.; Aliyu, S.R.; Lin, L.; Sekete, M.; Chen, X.; Otieno, F.J.; Yang, T.; Lin, Y.; Norvienyeku, J.; Wang, Z. Family-Four Aldehyde Dehydrogenases Play an Indispensable Role in the Pathogenesis of Magnaporthe oryzae. Front. Plant Sci. 2018, 9, 980. [Google Scholar] [CrossRef]
- Fan, J.; Huang, X.; Zheng, G.; Liu, C.; Wang, M.; Sun, Y.; Yang, Q. Knockout of the Aldehyde Dehydrogenase Gene in Fusarium oxysporum for Enhanced Ethanol Yield. Energies 2022, 16, 427. [Google Scholar] [CrossRef]
- Chen, Y.; Kistler, H.C.; Ma, Z. Fusarium graminearum Trichothecene Mycotoxins: Biosynthesis, Regulation, and Management. Annu. Rev. Phytopathol. 2019, 57, 15–39. [Google Scholar] [CrossRef] [PubMed]
- Proctor, R.H.; Hohn, T.M.; McCormick, S.P. Reduced virulence of Gibberella zeae caused by disruption of a trichothecene toxin biosynthetic gene. Mol. Plant-Microbe Interact. MPMI 1995, 8, 593–601. [Google Scholar] [CrossRef] [PubMed]
- Qin, J.; Wang, G.; Jiang, C.; Xu, J.-R.; Wang, C. Fgk3 glycogen synthase kinase is important for development, pathogenesis, and stress responses in Fusarium graminearum. Sci. Rep. 2015, 5, 8504. [Google Scholar] [CrossRef] [PubMed]
- Zheng, W.; Zhao, X.; Xie, Q.; Huang, Q.; Zhang, C.; Zhai, H.; Xu, L.; Lu, G.; Shim, W.; Wang, Z. A conserved homeobox transcription factor Htf1 is required for phialide development and conidiogenesis in Fusarium species. PLoS ONE 2012, 7, e45432. [Google Scholar] [CrossRef] [PubMed]
- Hou, Z.; Xue, C.; Peng, Y.; Katan, T.; Kistler, H.C.; Xu, J.-R. A mitogen-activated protein kinase gene (MGV1) in Fusarium graminearum is required for female fertility, heterokaryon formation, and plant infection. Mol. Plant-Microbe Interact. 2002, 15, 1119–1127. [Google Scholar] [CrossRef]
- Sun, S.; Wang, M.; Liu, C.; Tao, Y.; Wang, T.; Liang, Y.; Zhang, L.; Yu, J. FgLEU1 Is Involved in Leucine Biosynthesis, Sexual Reproduction, and Full Virulence in Fusarium graminearum. J. Fungi 2022, 8, 1090. [Google Scholar] [CrossRef]
- Li, Y.; Chen, D.; Luo, S.; Zhu, Y.; Jia, X.; Duan, Y.; Zhou, M. Intron-mediated regulation of β-tubulin genes expression affects the sensitivity to carbendazim in Fusarium graminearum. Curr. Genet. 2019, 65, 1057–1069. [Google Scholar] [CrossRef]
- Liu, J.; Li, J.; Gao, N.; Zhang, X.; Zhao, G.; Song, X. Identification and characterization of a protein Bro1 essential for sophorolipids synthesis in Starmerella bombicola. J. Ind. Microbiol. Biotechnol. 2020, 47, 437–448. [Google Scholar] [CrossRef]
- Wolszczak-Biedrzycka, B.; Zasimowicz-Majewska, E.; Bienkowska, A.; Biedrzycki, G.; Dorf, J.; Jelski, W. Activity of Total Alcohol Dehydrogenase, Alcohol Dehydrogenase Isoenzymes and Aldehyde Dehydrogenase in the Serum of Patients with Alcoholic Fatty Liver Disease. Medicina 2021, 58, 25. [Google Scholar] [CrossRef] [PubMed]
- Zaldívar-Machorro, V.J.; López-Ortiz, M.; Demare, P.; Regla, I.; Muñoz-Clares, R.A. The disulfiram metabolites S-methyl-N,N-diethyldithiocarbamoyl sulfoxide and S-methyl-N,N-diethylthiocarbamoyl sulfone irreversibly inactivate betaine aldehyde dehydrogenase from Pseudomonas aeruginosa, both in vitro and in situ, and arrest bacterial growth. Biochimie 2011, 93, 286–295. [Google Scholar] [CrossRef] [PubMed]
- Brakhage, A.A. Regulation of fungal secondary metabolism. Nat. Rev. Microbiol. 2013, 11, 21–32. [Google Scholar] [CrossRef] [PubMed]
- Hong, S.-Y.; Roze, L.; Linz, J. Oxidative Stress-Related Transcription Factors in the Regulation of Secondary Metabolism. Toxins 2013, 5, 683–702. [Google Scholar] [CrossRef] [PubMed]
- Roze, L.V.; Laivenieks, M.; Hong, S.-Y.; Wee, J.; Wong, S.-S.; Vanos, B.; Awad, D.; Ehrlich, K.C.; Linz, J.E. Aflatoxin Biosynthesis Is a Novel Source of Reactive Oxygen Species—A Potential Redox Signal to Initiate Resistance to Oxidative Stress? Toxins 2015, 7, 1411–1430. [Google Scholar] [CrossRef] [PubMed]
- Geisen, R.; Touhami, N.; Schmidt-Heydt, M. Mycotoxins as adaptation factors to food related environments. Curr. Opin. Food Sci. 2017, 17, 1–8. [Google Scholar] [CrossRef]
- Szymon, J.; Sebastian, K.; Gareth, C.; Jedrzej, S.; Alvaro, C.-I.; Dirk, S.; Joachim, S.; Lothar, W. Metabolomic and transcriptomic stress response of Escherichia coli. Mol. Syst. Biol. 2010, 6, 364. [Google Scholar] [CrossRef]
- Simone, M.R.; Maxuel, O.A.; Ana, P.S.G.; Fabio, M.D.; Maria, C.B.-P.; Elizabeth, P.B.F. Arabidopsis and tobacco plants ectopically expressing the soybean antiquitin-like ALDH7 gene display enhanced tolerance to drought, salinity, and oxidative stress. J. Exp. Bot. 2006, 57, 1909–1918. [Google Scholar] [CrossRef]
- Yang, H.; Zhang, D.; Wang, J.; Wood, A.J.; Zhang, Y. Molecular cloning of a stress-responsive aldehyde dehydrogenase gene ScALDH21 from the desiccation-tolerant moss Syntrichia caninervis and its responses to different stresses. Mol. Biol. Rep. 2012, 39, 2645–2652. [Google Scholar] [CrossRef]
- Shingo, I.; Yoshiharu, I. Post-transcriptional regulation of gene expression in yeast under ethanol stress. Biotechnol. Appl. Biochem. 2009, 53, 93–99. [Google Scholar] [CrossRef]
- Brocker, C.; Cantore, M.; Failli, P.; Vasiliou, V. Aldehyde dehydrogenase 7A1 (ALDH7A1) attenuates reactive aldehyde and oxidative stress induced cytotoxicity. Chem.-Biol. Interact. 2011, 191, 269–277. [Google Scholar] [CrossRef] [PubMed]
- Harris, L.J.; Desjardins, A.E.; Plattner, R.D.; Nicholson, P.; Butler, G.; Young, J.C.; Weston, G.; Proctor, R.H.; Hohn, T.M. Possible Role of Trichothecene Mycotoxins in Virulence of Fusarium graminearum on Maize. Plant Dis. 1999, 83, 954–960. [Google Scholar] [CrossRef] [PubMed]
- Buchanan, R.L.; Jones, S.B.; Gerasimowicz, W.V.; Zaika, L.L.; Stahl, H.G.; Ocker, L.A. Regulation of aflatoxin biosynthesis: Assessment of the role of cellular energy status as a regulator of the induction of aflatoxin production. Appl. Environ. Microbiol. 1987, 53, 1224–1231. [Google Scholar] [CrossRef] [PubMed]
- Cederbaum, A.I. Alcohol Metabolism. Clin. Liver Dis. 2012, 16, 667–685. [Google Scholar] [CrossRef] [PubMed]
- Zou, L.; Hu, Y.; Chen, W. Antibacterial mechanism and activities of black pepper chloroform extract. J. Food Sci. Technol. 2015, 52, 8196–8203. [Google Scholar] [CrossRef]
- Wilfling, F.; Haas, J.T.; Walther, T.C.; Farese, R.V., Jr. Lipid droplet biogenesis. Curr. Opin. Cell Biol. 2014, 29, 39–45. [Google Scholar] [CrossRef] [PubMed]
- Nguyen, L.N.; Hamari, Z.; Kadereit, B.; Trofa, D.; Agovino, M.; Martinez, L.R.; Gacser, A.; Silver, D.L.; Nosanchuk, J.D. Candida parapsilosis fat storage-inducing transmembrane (FIT) protein 2 regulates lipid droplet formation and impacts virulence. Microbes Infect. 2011, 13, 663–672. [Google Scholar] [CrossRef] [PubMed]
- Wang, S.; Fang, W.; Wang, C.; St, L.R.J. Insertion of an esterase gene into a specific locust pathogen (Metarhizium acridum) enables it to infect caterpillars. PLoS Pathog. 2011, 7, e1002097. [Google Scholar] [CrossRef]
- Zeng, X.; Chen, G.; Liu, X.; Dong, B.; Shi, H.; Lu, J.; Lin, F. Crosstalk between SNF1 pathway and the peroxisome-mediated lipid metabolism in Magnaporthe oryzae. PLoS ONE 2014, 9, e103124. [Google Scholar] [CrossRef]
- Kim, J.-E.; Jin, J.; Kim, H.; Kim, J.-C.; Yun, S.-H.; Lee, Y.-W. GIP2, a putative transcription factor that regulates the aurofusarin biosynthetic gene cluster in Gibberella zeae. Appl. Environ. Microbiol. 2006, 72, 1645–1652. [Google Scholar] [CrossRef]
- Kim, Y.-T.; Lee, Y.-R.; Jin, J.; Han, K.-H.; Kim, H.; Kim, J.-C.; Lee, T.; Yun, S.-H.; Lee, Y.-W. Two different polyketide synthase genes are required for synthesis of zearalenone in Gibberella zeae. Mol. Microbiol. 2005, 58, 1102–1113. [Google Scholar] [CrossRef] [PubMed]
- Seong, K.-Y.; Pasquali, M.; Zhou, X.; Song, J.; Hilburn, K.; McCormick, S.; Dong, Y.; Xu, J.-Y.; Kistler, H.C. Global gene regulation by Fusarium transcription factors Tri6 and Tri10 reveals adaptations for toxin biosynthesis. Mol. Microbiol. 2009, 72, 354–367. [Google Scholar] [CrossRef] [PubMed]
- Jawad, M.; Florence, R.-F.; Christian, B. The pH regulatory factor Pac1 regulates Tri gene expression and trichothecene production in Fusarium graminearum. Fungal Genet. Biol. 2011, 48, 275–284. [Google Scholar] [CrossRef]
- Erik, L.; Matias, P.; Andrew, B.; Corby, K.H. The transcription factor FgStuAp influences spore development, pathogenicity, and secondary metabolism in Fusarium graminearum. Mol. Plant-Microbe Interact. MPMI 2011, 24, 54–67. [Google Scholar] [CrossRef]
- Wang, Y.; Liu, W.; Hou, Z.; Wang, C.; Zhou, X.; Jonkers, W.; Ding, S.; Corby, K.H.; Xu, J.-R. A novel transcriptional factor important for pathogenesis and ascosporogenesis in Fusarium graminearum. Mol. Plant-Microbe Interact. MPMI 2011, 24, 118–128. [Google Scholar] [CrossRef] [PubMed]
- Lee, K.-M.; Cho, W.K.; Yu, J.; Son, M.; Choi, H.; Min, K.; Lee, Y.-W.; Kim, K.-H. A comparison of transcriptional patterns and mycological phenotypes following infection of Fusarium graminearum by four mycoviruses. PLoS ONE 2014, 9, e100989. [Google Scholar] [CrossRef] [PubMed]
- Yu, J.; Kim, K.-H. A Phenome-Wide Association Study of the Effects of Fusarium graminearum Transcription Factors on Fusarium Graminearum Virus 1 Infection. Front. Microbiol. 2021, 12, 622261. [Google Scholar] [CrossRef]
- Puri, K.D.; Yan, C.; Leng, Y.; Zhong, S. RNA-Seq Revealed Differences in Transcriptomes between 3ADON and 15ADON Populations of Fusarium graminearum In Vitro and In Planta. PLoS ONE 2016, 11, e0163803. [Google Scholar] [CrossRef]
- Guo, L.; Zhao, G.; Xu, J.-R.; Corby, K.H.; Gao, L.; Ma, L.-J. Compartmentalized gene regulatory network of the pathogenic fungus Fusarium graminearum. New Phytol. 2016, 211, 527–541. [Google Scholar] [CrossRef]
- Sorbo, G.D.; Schoonbeek, H.-j.; Waard, M.A.D. Fungal Transporters Involved in Efflux of Natural Toxic Compounds and Fungicides. Fungal Genet. Biol. 2000, 30, 1–15. [Google Scholar] [CrossRef]
- Kovalchuk, A.; Driessen, A.J.M. Phylogenetic analysis of fungal ABC transporters. BMC Genom. 2010, 11, 177. [Google Scholar] [CrossRef] [PubMed]
- Ammar, G.A.; Tryono, R.; Döll, K.; Karlovsky, P.; Deising, H.B.; Wirsel, S.G.R. Identification of ABC transporter genes of Fusarium graminearum with roles in azole tolerance and/or virulence. PLoS ONE 2013, 8, e79042. [Google Scholar] [CrossRef] [PubMed]
- Li, T.; Kim, J.-H.; Jung, B.; Ji, S.; Seo, M.W.; Han, Y.K.; Lee, S.W.; Bae, Y.S.; Choi, H.-G.; Lee, S.-H.; et al. Transcriptome analyses of the ginseng root rot pathogens Cylindrocarpon destructans and Fusarium solani to identify radicicol resistance mechanisms. J. Ginseng Res. 2020, 44, 161–167. [Google Scholar] [CrossRef]
- Becher, R.; Weihmann, F.; Deising, H.B.; Wirsel, S.G. Development of a novel multiplex DNA microarray for Fusarium graminearum and analysis of azole fungicide responses. BMC Genom. 2011, 12, 52. [Google Scholar] [CrossRef] [PubMed]
- Lee, J.I.; Yu, Y.M.; Rho, Y.M.; Park, B.C.; Choi, J.H.; Park, H.M.; Maeng, P.J. Differential expression of the chsE gene encoding a chitin synthase of Aspergillus nidulans in response to developmental status and growth conditions. FEMS Microbiol. Lett. 2005, 249, 121–129. [Google Scholar] [CrossRef] [PubMed]
- Kim, J.-E.; Lee, H.-J.; Lee, J.; Kim, K.W.; Yun, S.-H.; Shim, W.-B.; Lee, Y.-W. Gibberella zeae chitin synthase genes, GzCHS5 and GzCHS7, are required for hyphal growth, perithecia formation, and pathogenicity. Curr. Genet. 2009, 55, 449–459. [Google Scholar] [CrossRef] [PubMed]
- Zhang, Y.-Z.; Chen, Q.; Liu, C.-H.; Liu, Y.-B.; Yi, P.; Niu, K.-X.; Wang, Y.-Q.; Wang, A.-Q.; Yu, H.-Y.; Pu, Z.-E.; et al. Chitin synthase gene FgCHS8 affects virulence and fungal cell wall sensitivity to environmental stress in Fusarium graminearum. Fungal Biol. 2016, 120, 764–774. [Google Scholar] [CrossRef]

| Gene Category | Log2(fc) | p-Value | Function |
|---|---|---|---|
| Transcription factors | |||
| FGSG_00217 | −1.0766 | 3.25 × 10−2 | Transcription factors |
| FGSG_03873 | −1.1957 | 4.47 × 10−2 | Transcription factors |
| FGSG_03649 | −1.3199 | 4.25 × 10−2 | Transcription factors |
| FGSG_00713 | 1.1959 | 5.61 × 10−3 | Transcription factors |
| Aurofusarin biosynthesis gene cluster | |||
| FGSG_02322 | −1.2654 | 3.06 × 10−2 | GIP4/AurT |
| FGSG_02323 | −1.3355 | 1.17 × 10−2 | GIP5/AurR2 |
| Transporter-related genes | |||
| FGSG_02263 | −2.8354 | 2.78 × 10−2 | ABC-type transporter |
| FGSG_03571 | −3.4838 | 2.88 × 10−2 | MFS-type efflux pump MFS1 |
| FGSG_09595 | −1.9665 | 3.41 × 10−2 | MFS-type transporter |
| FGSG_10923 | −1.7986 | 5.82 × 10−5 | Efflux pump himE |
| FGSG_03882 | 1.1826 | 1.03 × 10−2 | ABC multidrug transporter |
| FGSG_02966 | 1.4650 | 2.21 × 10−4 | MFS-type efflux pump MFS2 |
| FGSG_07802 | 1.1539 | 3.86 × 10−4 | Efflux pump FUS6 |
| Hydrophobic protein | |||
| FGSG_09066 | 1.0376 | 2.92 × 10−2 | Hydrophobin 3 precursor |
| Chitin-synthesis-related genes | |||
| FGSG_03418 | 1.4372 | 1.48 × 10−4 | Chitin synthase 1 |
| FGSG_08673 | 1.4138 | 2.16 × 10−4 | Chitin synthase regulator 2 |
| FGSG_03544 | −1.0391 | 5.29 × 10−3 | Chitin deacetylase |
| Energy-metabolism-related genes | |||
| FGSG_08774 | 1.4856 | 3.92 × 10−4 | Glucokinase |
| FGSG_08399 | 1.2927 | 4.51 × 10−3 | Hexokinase-1 |
| FGSG_01743 | 1.4074 | 9.58 × 10−4 | Acetyl-coenzyme A synthetase |
| FGSG_08343 | 1.2453 | 5.91 × 10−3 | Plasma membrane ATPase |
| FGSG_01522 | 1.9596 | 2.29 × 10−6 | Adenylate cyclase |
| Other protein-related genes | |||
| FGSG_01582 | 6.1298 | 1.01 × 10−39 | RNA-dependent RNA polymerase 1 |
| FGSG_04619 | 6.4425 | 4.17 × 10−39 | RNA-dependent RNA polymerase 1 |
| FGSG_13459 | −4.6314 | 8.34 × 10−3 | Cytochrome P450 monooxygenase |
| FGSG_03264 | −1.9838 | 1.02 × 10−2 | Cytochrome P450 monooxygenase |
Disclaimer/Publisher’s Note: The statements, opinions and data contained in all publications are solely those of the individual author(s) and contributor(s) and not of MDPI and/or the editor(s). MDPI and/or the editor(s) disclaim responsibility for any injury to people or property resulting from any ideas, methods, instructions or products referred to in the content. |
© 2023 by the authors. Licensee MDPI, Basel, Switzerland. This article is an open access article distributed under the terms and conditions of the Creative Commons Attribution (CC BY) license (https://creativecommons.org/licenses/by/4.0/).
Share and Cite
Tang, L.; Zhai, H.; Zhang, S.; Lv, Y.; Li, Y.; Wei, S.; Ma, P.; Wei, S.; Hu, Y.; Cai, J. Functional Characterization of Aldehyde Dehydrogenase in Fusarium graminearum. Microorganisms 2023, 11, 2875. https://doi.org/10.3390/microorganisms11122875
Tang L, Zhai H, Zhang S, Lv Y, Li Y, Wei S, Ma P, Wei S, Hu Y, Cai J. Functional Characterization of Aldehyde Dehydrogenase in Fusarium graminearum. Microorganisms. 2023; 11(12):2875. https://doi.org/10.3390/microorganisms11122875
Chicago/Turabian StyleTang, Lei, Huanchen Zhai, Shuaibing Zhang, Yangyong Lv, Yanqing Li, Shan Wei, Pingan Ma, Shanshan Wei, Yuansen Hu, and Jingping Cai. 2023. "Functional Characterization of Aldehyde Dehydrogenase in Fusarium graminearum" Microorganisms 11, no. 12: 2875. https://doi.org/10.3390/microorganisms11122875
APA StyleTang, L., Zhai, H., Zhang, S., Lv, Y., Li, Y., Wei, S., Ma, P., Wei, S., Hu, Y., & Cai, J. (2023). Functional Characterization of Aldehyde Dehydrogenase in Fusarium graminearum. Microorganisms, 11(12), 2875. https://doi.org/10.3390/microorganisms11122875

